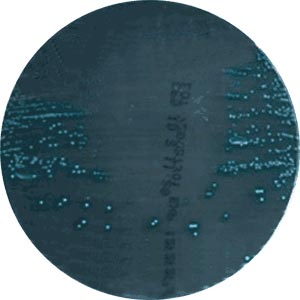
effet antibactérien des urines

ECBU facultative |
ECBU indispensable |
|
| Sujet | Femme (adulte) Moins de 65 ans En dehors de la grossesse Sans anomalie urologique connue En l’absence de récidives (> 4 cystites/an ou dernière cystite <3mois) |
Homme – Enfant – femme enceinte Sujet âgé de plus de 65 ans Présence d’anomalie urologique Cystite aiguë récidivante (> 4 cystites/an ou dernière cystite <3mois) Sujet diabétique mal équilibré Sujet immunodéprimé Après échec d’un traitement minute |
| Clinique | Cystite aiguë non compliquée : brûlure mictionnelle, pollakiurie, urines troubles ou hématuriques mais absence de fièvre, de frissons, de douleurs lombaires | Cystite aiguë compliquée ou pyélonéphrite : hyperthermie, frissons, douleurs lombaires |
| Bandelette urinaire | Leucocytes + Nitrites + |
Absence de leucocyte +/- nitrites |
| Traitement | Cure de diurèse + antibiothérapie à dose unique (traitement minute) : Fosfomycine – Trométamol (Monuril®), Ofloxacine, Péfloxacine, Ciprofloxacine voir Cotrimoxazole en dose unique ou en traitement de 3j | A adapter en fonction du germe identifié et de l’antibiogramme |
| Suivi | Une consultation est indispensable en cas d’échec clinique (persistance des signes cliniques après le 2-3ème jour) ou de rechute précoce | Une consultation est indispensable en cas d’échec clinique (persistance des signes cliniques après le 2-3ème jour) ou de rechute précoce |
-
Lavage de mains + lavage soigneux au savon ou antiseptique doux de la vulve
chez la femme et du méat urétral chez l’homme + rinçage
-
Eliminer le 1er jet d’urine (~20mL)
-
Recueillir le 2ème jet (~20mL) dans un flacon stérile
-
Identification et transport immédiat au laboratoire (éventuellement
conservation quelques heures à 4°C ou utilisation d’un tube boraté contenant
un conservateur).
L’urine du 1er jet peut être recueillie (éventuellement après massage prostatique) en cas de suspicion d’infection urétrale ou prostatique.
Urines
normales |
Infection
urinaire |
Urines
contaminées |
|
| Leucocytes | < 10 000/mL |
Généralement > 50 000/mL |
Variable |
| Hématies | < 5 000/mL |
Généralement > 10 000/mL |
Variable |
| Autres éléments | Cellules urothéliales Cellules épithéliales pavimenteuses Cylindres granuleux |
Cellules épithéliales d’origine vaginale |
|
| Micro-organismes | Absence de bactériurie (ou généralement < 103 UFC/mL) |
Généralement > 105 UFC/mL Généralement un seul type de germes |
Généralement <104 UFC/mL Généralement plusieurs types de germes |
- Présence d’une bactériurie mais absence de leucocytes :
- infection urinaire débutante
- sujet immunodéprimé (chimiothérapie …)
Présence de leucocytes (> 104/mL) mais absence de bactérie :
- sujet ayant pris un traitement antibiotique
- présence de germes exigeants : Mycobacterium tuberculosis
- présence de leucocytes génitaux
Au
cours des règles, le trigone vésical (tout comme la muqueuse utérine)
desquame.
La présence de cellules épithéliales supposées d’origine vaginale
chez une femme en période menstruelle ne doit pas être interprétée
systématiquement comme un signe de contamination.
Une technique d’ensemencement permet une quantification :

Une estimation de la numération bactérienne sera établie après 24H à 37°C :

Attention, l’estimation visuelle de la numération bactérienne peut être une
source d’erreur : principalement
- surestimation des grosses colonies
- sous-estimation des petites colonies
Il
peut être alors nécessaire dans certains cas de compter les colonies : dans
cette technique, la gélose est ensemencée à partir d’une oëse de 10µL donc 1
colonie = 102 UFC/mL.
D’autres techniques de numération peuvent être utilisées : technique des
dilutions, technique de la lame immergée …
L’aspect de la pousse bactérienne peut mettre en évidence un effet antibactérien des urines (évoquant la présence d’un antibiotique dans les urines) : effet dit « carry over ».

| Infection urinaire communautaire (%) | Infection urinaire nosocomiale (%) | |
| E. coli | 80 (40% résistant à l'amoxicilline) |
50 (> 50% résistant à l'amoxicilline) |
| Proteus spp., KES … | 10 |
25 |
| Staphylococcus spp. | 2-3 |
4 |
| Streptococcus spp. | 1 |
7 |
| Pseudomonas aeruginosa | - |
10-20 |
| Candida spp. | - |
2 |
Source : http://www.infectiologie.com/site/medias/enseignement/popi2003.pdf
Les bactéries retrouvées dans les urines sont classées en fonction de leur capacité à provoquer une infection urinaire :
Groupe I (uropathogènes reconnus) :
Escherichia coli, Staphylococcus saprophyticus (surtout chez la femme jeune), Salmonella spp. (rare) et Mycobactérie (rare)
Groupe II (bactéries moins fréquemment responsables d’infection urinaire) :
souvent infection nosocomiale avec présence de facteurs favorisants : autres entérobactéries (Klebsiella spp., Proteus spp., Enterobacter spp., Morganella spp.), Enterococcus spp, Pseudomonas aeruginosa, Staphylococcus aureus, Corynebacterium urealyticum, Haemophilus spp. (rare), Streptococcus spp. (rare)
Groupe III (bactéries qu’il faut considérer comme pathogènes si elles sont isolées à plusieurs reprises avec des bactériuries ≥ 105 UFC/mL) :
Streptococcus agalactiae, Candida spp. (surtout C. albicans et C. glabrata), Staphylocoques coagulase négative (sauf S. saprophyticus), Acinetobacter baumannii, Stenotrophomonas maltophilia, Burkholderia cepacia, Olligella urethralis, Aerococcus urinae
Groupe IV (bactéries de la flore uréthrale ou génitale de proximité) :
Streptocoques alpha hémolytiques, Gardnerella vaginalis, Lactobacillus spp., bacilles corynéformes (sauf Corynebacterium urealyticum)
Leucocyturie |
Bactériurie |
Type de colonies |
Interprétation |
Conduite à tenir |
| Non | Non | 0 | ECBU stérile | Aucune |
| Oui | Non | 0 | Traitement antibiotique Bactérie exigeante (BK) Leucocytes génitaux | A refaire en adaptant les techniques |
| Non | Oui | 1 sorte | Infection débutante Infection aplasique Contamination | Identification + antibiogramme ou à contrôler |
| Oui | Oui | 1 sorte | Infection typique | Identification et antibiogramme |
| Non | Non | > 1 sorte | Souillure | Aucune |
| Oui | Non | ≥ 2 sortes | Infection sur sonde ? | A contrôler |
| Non | Oui | ≥ 2 sortes | Souillure | Aucune |
| Oui | Oui | ≥ 2 sortes | Infection polymicrobienne ? | A refaire |
Assurer une rétention urinaire de 4 à 8H (sinon risque de faux négatif pour
les nitrites si bactériurie trop faible).
L’antibiothérapie doit être suspendue 3j avant le test
Positif à partir de 3 hématies/mL
Faux positif : hémoglobinurie, myoglobinurie, eau de javel
Positif à partir de 10-25 leucocytes/mL
Faux négatif : très forte concentration de glucose, certains antibiotiques :
Céfalotine, Céfalexine, Tétracycline … Faux positif : certains antibiotiques : Carbapénèmes, Acide clavulanique …
Réaction spécifique des nitrites : met indirectement en évidence la présence
de germe possédant une nitrate réductase.
On peut observer des faux négatifs
en cas d’absence de nitrate dans les urines.
La
bandelette urinaire présente un bon pouvoir prédictif négatif.
Milieux de culture : http://www2.ac-lyon.fr/enseigne/biotech/microbio/milieux.html
Bandelette urinaire : http://www.nephrohus.org/s/spip.php?article187